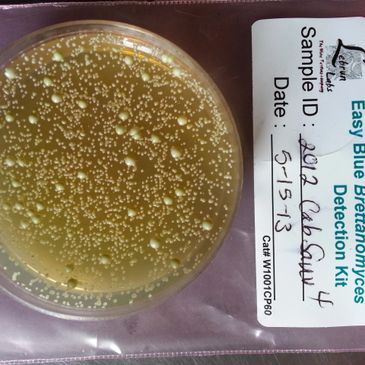

To make great wine, we start with a well balanced vine which will produce superior fruit.
Many problems may be mitigated if you know about it soon enough. You may have an idea something is off but are not sure what. I have the ability to test many aspects of the wine using my Enolyzer Wine Analyzer, pH meter, and other testing methods and possibly correct imbalances before they become unusable.

What goes in the bottle should be the best you have. Quality grapes, production procedures and good customer service will assure your customers will keep coming back for more.

My experience allows me to take you from the vineyard, through harvest. Training can be customized to your needs. I can then walk you through the process of selling your wine in your tasting room and beyond.
I can train you to do some of your own testing such as copper trials for H2S, Photochromotography for Malolactic Fermentation Progress and utilize equipment you have purchased.
Hourly Rate: $75
Hourly and Testing Rates Are Subject to Change
Testing Procedures Available
Labels and Label Applicator
Discounts on lab tests are available if client is paying an hourly rate (whichever is less for client).
More testing procedures available but pricing is